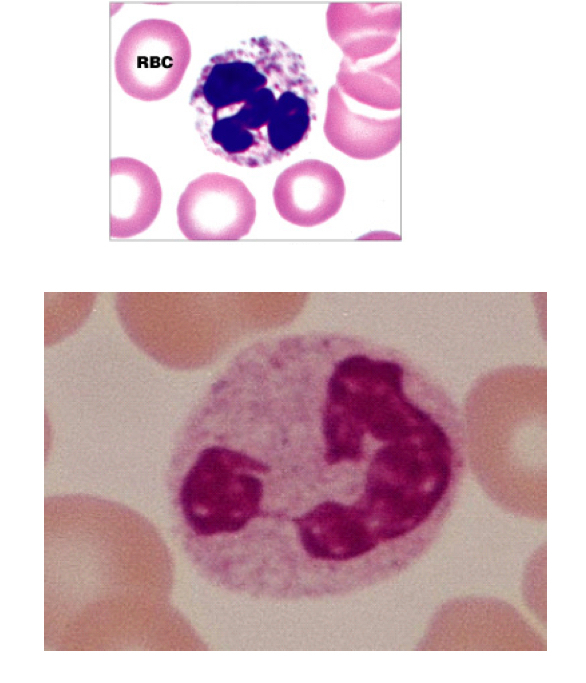
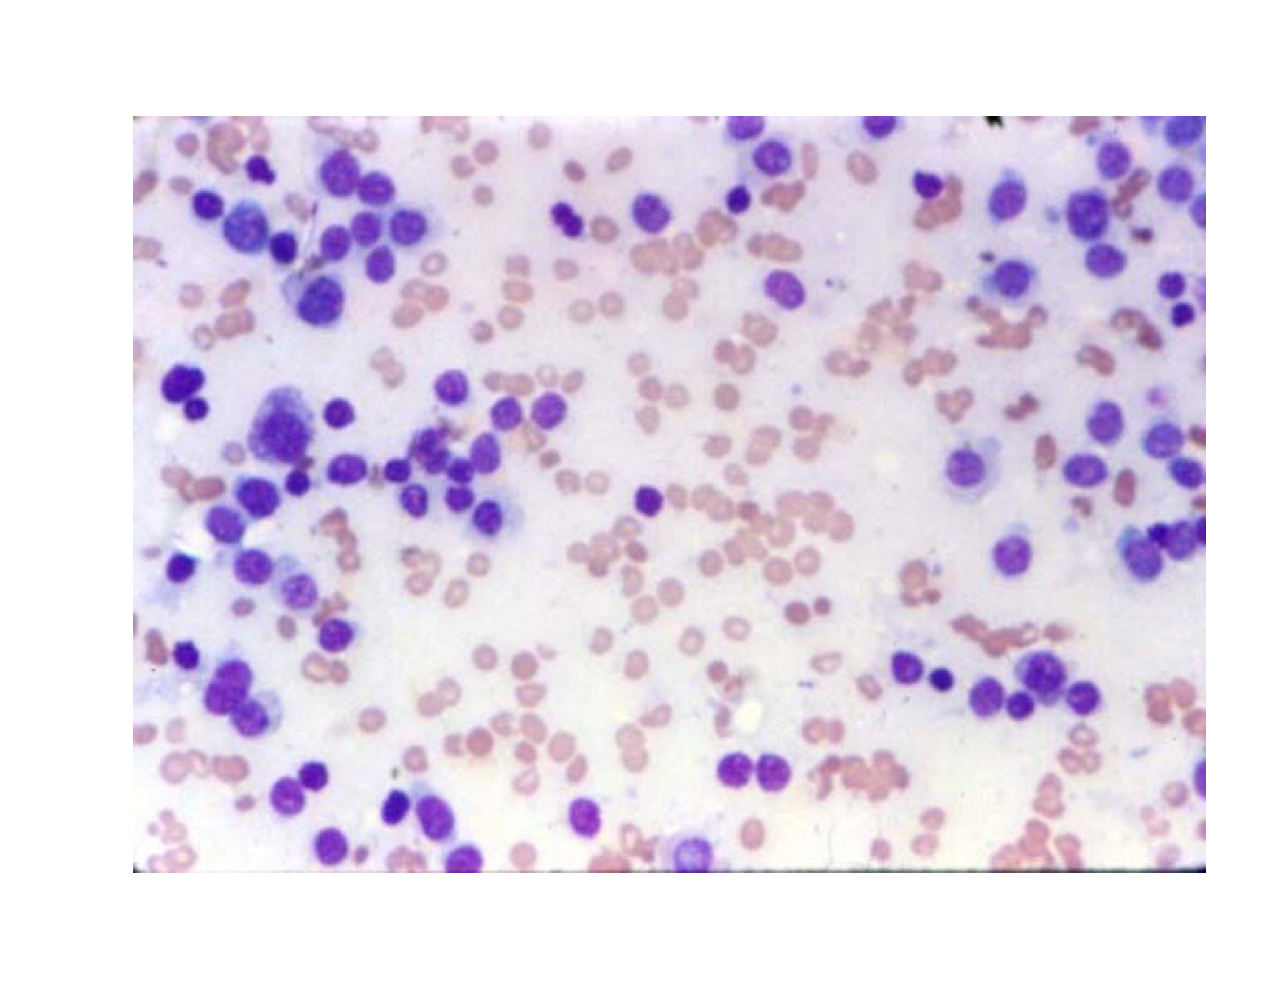

What cell is this? Does it perform phagocytosis and/or does it have granules?
neutrophil - most common
phagocytosis, contains granules
What cell is this? Does it perform phagocytosis and/or does it have granules?

eosinophil - horse shoe, parasitic
phagocytosis, contains granules
What cell is this? Does it perform phagocytosis and/or does it have granules?

basophil - least common
associated with allergies
NOT phagocytic, contains granules
What cell is this? Does it perform phagocytosis and/or does it have granules?

lymphocyte - specific immunity
- no granules
B cells phagocytic, T cells not
What cell is this? Does it perform phagocytosis and/or does it have granules?

monocyte - large indented nucleus
phagocytic, no granules
What disorder is this?
leukemia
What disorder is this?

multiple myeloma
What is this structure and where would you find it? What does it absorb?

lacteal - lymphatic capillary found in the villi of the small intestine
- absorbs lipids
What is this cell and where would you find it?

plasma cell - activated B cell
found in spleen, lymph, or extracellular fluid
What is this cell and what are the circled structures? What are on the outside of the cell?

macrophage - derives from monocytes
- circled structures: lysosomes
- contain pseudopodia to engulf bacteria
can participate in specific defense - APC
What are these fibers and what are they made out of? What cells make them?

reticular fibers made by reticular cell
- made out of collagen
- support cell - support lymphatic organs and slows fluid flow to increase time for lymphocytes to be exposed to liquid
What kind of tissue is this and where would you find it?

diffuse lymphatic tissue
- contains high [lymphocytes]
- found in reticular fibers in loose CT of almost every organ
What is this structure? What cells would you find in A and B?

lymphatic follicle - unencapsulated clusters of reticular fibers and lymphocytes/macrophages
- Peyer’s patches, appendix
- A: germinal center - contains B cells that can be activated into plasma cells and dendritic cells
- B: T cells
Identify the following structures. What are the structures that are unique to this organ?

A - afferent lymphatics*
B - efferent lymphatics
C - hilus
D - lymphoid follicle
E - germinal center
F - sub capsular sinus
G - medullary cord*
H - medullary sinus*
I - trabeculae
Identify these organs. What are the ones that typically get removed?

Tonsils
A - nasopharyngeal - psuedostratified
B - palatine - paired, typically removed
- stratified
C - lingual - paired
- stratified
What are these structures?

nasopharyngeal tonsil
enlarged palatine tonsil
Identify these structures

A - tonsil
B - crypt
C - geminal centers in lymphoid follicle
Identify these structures. What organ is this?

A - central arteriole
B - white pulp - PALS
- periarteriole lymphatic sheath
C - red pulp - RBC/platelet storage/metabolism
spleen - only organ that filters blood
What organ is this and what does it release?

thymus
releases thymosin - stimulates development of T cells
What is this organ and what occurs at A and B?

thymus
- B - positive T cell selection: T cell must react to MHCI/II to survive
- A - negative T cell selection: T cell cannot respond too strongly to self antigens to survive
What are the three following actions of antibodies?

- neutralization
- opsonization
- agglutination
Identify the following structures

A. lesser omentum
B. greater omentum
C. mesocolon
D. mesentery proper
identify the following structues

A. lesser omentum
B. greater omentum
C. mesentery proper
D. root of mesentery
E. transverse mesocolon
Identify these structures. What is located in C?

A. lesser omentum
B. greater omentum
C. hepatic artery, portal vein, common bile duct




























